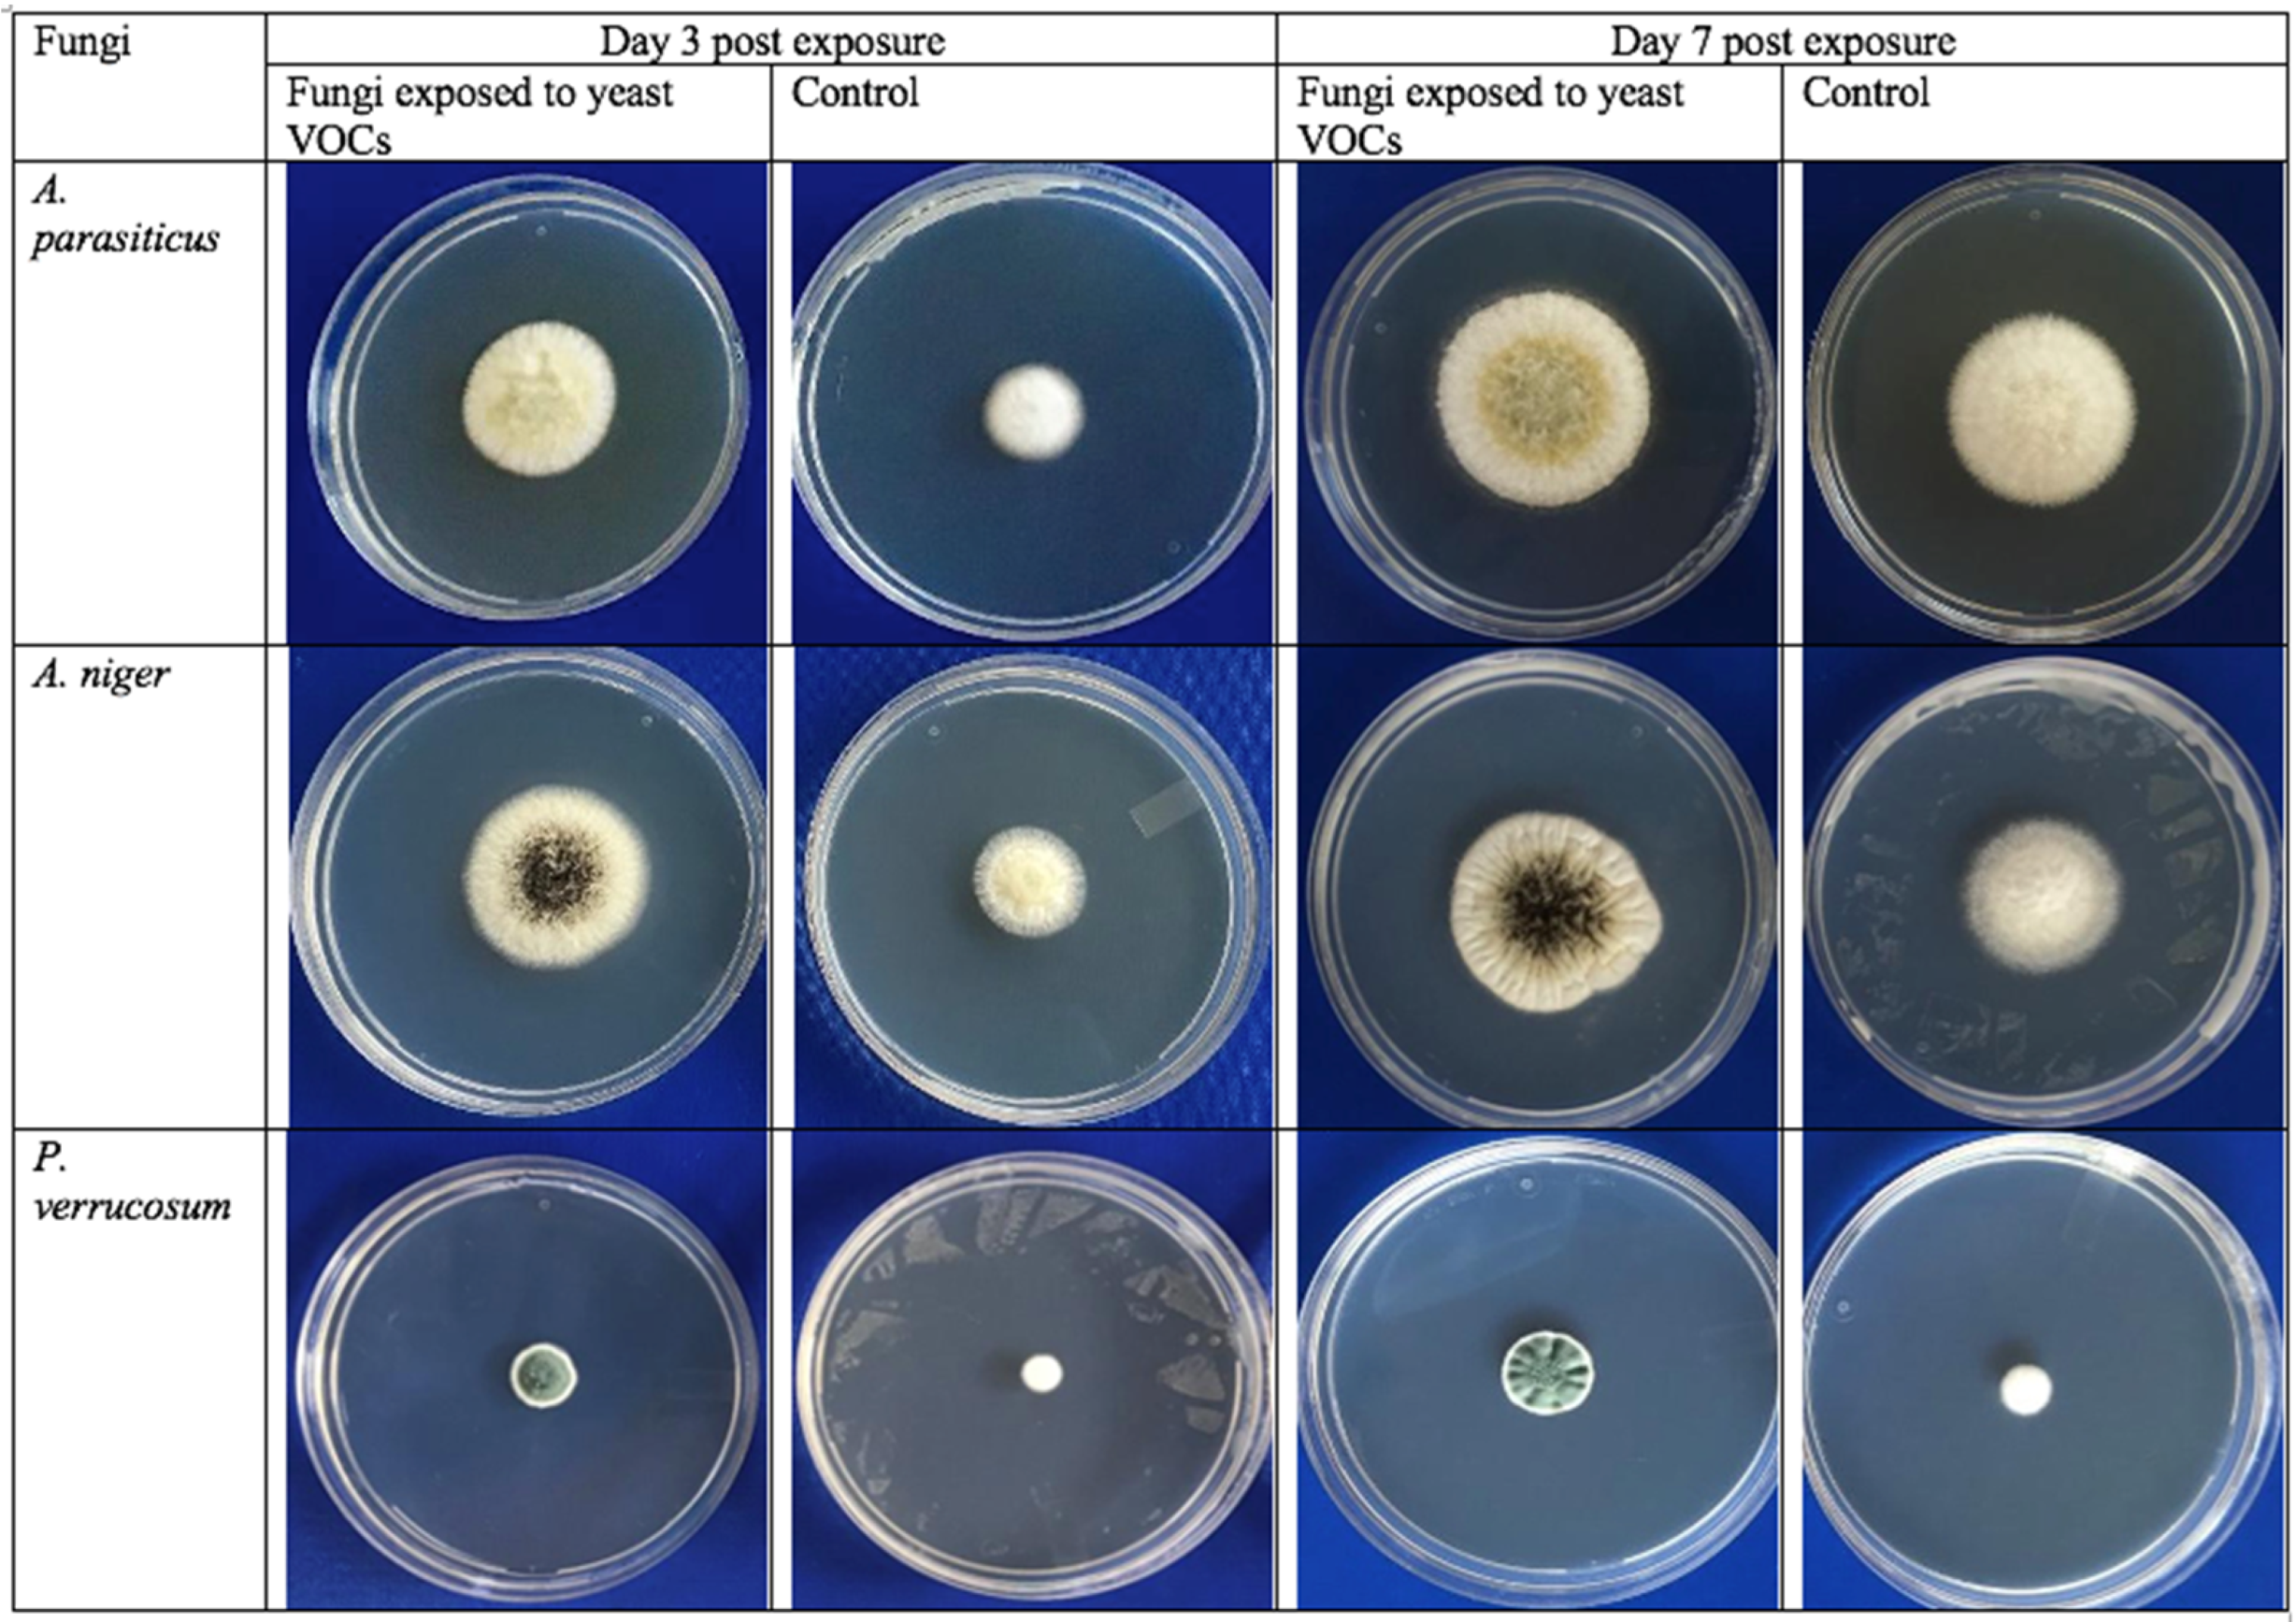

Occurrence of Mycotoxins and Toxigenic Fungi in Cereals and Application of Yeast Volatiles for Their Biological Control
Abstract
:1. Introduction
2. Results and Discussion
2.1. Fungal Contamination of Cereal Samples
2.2. Morphological Identification of the Isolated Fungi
2.3. Molecular Identification of Mycotoxigenic Fungi Isolated from Cereal Samples
2.4. Levels of AFs and OTA in Cereals
2.5. Effects of Cyberlindnera Jadinii 273 Volatiles on Fungal Growth
3. Conclusions
4. Materials and Methods
4.1. Material and Supplies
4.2. Sampling
4.3. Isolation and Morphological Identification of Fungi
4.4. Molecular Identification of Fungi Isolated from the Cereal Samples
4.5. Monitoring of Aflatoxins (AFs) and Ochratoxin A (OTA) in Cereal Samples
4.6. Biocontrol of Toxigenic Fungi Using Antagonistic Yeast (Cyberlindnera jadinii 273) Volatiles
4.7. Statistical Analysis
Author Contributions
Funding
Institutional Review Board Statement
Informed Consent Statement
Data Availability Statement
Acknowledgments
Conflicts of Interest
References
- Tacer-Caba, Z.; Nilufer-Erdil, D.; Ai, Y. Chemical Composition of Cereals and Their Products. In Handbook of Food Chemistry; Cheung, P.C.K., Mehta, B.M., Eds.; Springer: Berlin/Heidelberg, Germany, 2015; pp. 1–23. ISBN 978-3-642-41609-5. [Google Scholar]
- Laskowski, W.; Górska-Warsewicz, H.; Rejman, K.; Czeczotko, M.; Zwolińska, J. How Important Are Cereals and Cereal Products in the Average Polish Diet? Nutrients 2019, 11, 679. [Google Scholar] [CrossRef] [PubMed] [Green Version]
- Food and Agriculture Organization (FAO). World Agriculture: Towards 2015/2030: Summary Report; FAO: Rome, Italy, 2002. [Google Scholar]
- FAO. Crop Prospects and Food Situation; Quarterly Global Report No. 4, December 2021; FAO: Rome, Italy, 2021. [Google Scholar] [CrossRef]
- Oliveira, G.; da Silva, D.M.; Alvarenga Pereira, R.G.F.; Paiva, L.C.; Prado, G.; Batista, L.R. Effect of Different Roasting Levels and Particle Sizes on Ochratoxin A Concentration in Coffee Beans. Food Control 2013, 34, 651–656. [Google Scholar] [CrossRef] [Green Version]
- Palma-Guerrero, J.; Chancellor, T.; Spong, J.; Canning, G.; Hammond, J.; McMillan, V.E.; Hammond-Kosack, K.E. Take-All Disease: New Insights into an Important Wheat Root Pathogen. Trends Plant Sci. 2021, 26, 836–848. [Google Scholar] [CrossRef]
- Różewicz, M.; Wyzińska, M.; Grabiński, J. The Most Important Fungal Diseases of Cereals—Problems and Possible Solutions. Agronomy 2021, 11, 714. [Google Scholar] [CrossRef]
- Cimbalo, A.; Alonso-Garrido, M.; Font, G.; Manyes, L. Toxicity of Mycotoxins in Vivo on Vertebrate Organisms: A Review. Food Chem. Toxicol. 2020, 137, 111161. [Google Scholar] [CrossRef]
- Abdulkadar, A.H.W.; Al-Ali, A.A.; Al-Kildi, A.M.; Al-Jedah, J.H. Mycotoxins in Food Products Available in Qatar. Food Control 2004, 15, 543–548. [Google Scholar] [CrossRef]
- Hassan, Z.U.; Al-Thani, R.F.; Migheli, Q.; Jaoua, S. Detection of Toxigenic Mycobiota and Mycotoxins in Cereal Feed Market. Food Control 2018, 84, 389–394. [Google Scholar] [CrossRef]
- Hassan, Z.U.; Al Thani, R.; Balmas, V.; Migheli, Q.; Jaoua, S. Prevalence of Fusarium Fungi and Their Toxins in Marketed Feed. Food Control 2019, 104, 224–230. [Google Scholar] [CrossRef]
- Alshannaq, A.; Yu, J.-H. Occurrence, Toxicity, and Analysis of Major Mycotoxins in Food. Int. J. Environ. Res. Public Health 2017, 14, 632. [Google Scholar] [CrossRef] [Green Version]
- Ul Hassan, Z.; Al Thani, R.; Atia, F.A.; Al Meer, S.; Migheli, Q.; Jaoua, S. Co-Occurrence of Mycotoxins in Commercial Formula Milk and Cereal-Based Baby Food on the Qatar Market. Food Addit. Contam. Part B 2018, 11, 191–197. [Google Scholar] [CrossRef]
- Neme, K.; Mohammed, A. Mycotoxin Occurrence in Grains and the Role of Postharvest Management as a Mitigation Strategies. A Review. Food Control 2017, 78, 412–425. [Google Scholar] [CrossRef]
- Ul-Hassan, Z.; Zargham Khan, M.; Khan, A.; Javed, I. Immunological Status of the Progeny of Breeder Hens Kept on Ochratoxin A (OTA)- and Aflatoxin B1 (AFB1)-Contaminated Feeds. J. Immunotoxicol. 2012, 9, 381–391. [Google Scholar] [CrossRef] [PubMed] [Green Version]
- Kifer, D.; Jakšić, D.; Šegvić Klarić, M. Assessing the Effect of Mycotoxin Combinations: Which Mathematical Model Is (the Most) Appropriate? Toxins 2020, 12, 153. [Google Scholar] [CrossRef] [PubMed] [Green Version]
- Smith, M.-C.; Madec, S.; Coton, E.; Hymery, N. Natural Co-Occurrence of Mycotoxins in Foods and Feeds and Their in vitro Combined Toxicological Effects. Toxins 2016, 8, 94. [Google Scholar] [CrossRef]
- Pitt, J.I.; Hocking, A.D. Fungi and Food Spoilage, 3rd ed.; Springer: New York, NY, USA, 2009. [Google Scholar] [CrossRef]
- Susca, A.; Villani, A.; Moretti, A.; Stea, G.; Logrieco, A. Identification of Toxigenic Fungal Species Associated with Maize Ear Rot: Calmodulin as Single Informative Gene. Int. J. Food Microbiol. 2020, 319, 108491. [Google Scholar] [CrossRef]
- Krulj, J.; Ćurčıć, N.; Stančıć, A.B.; Kojıć, J.; Pezo, L.; Tukuljac, L.P.; Solarov, M.B. Molecular Identification and Characterisation of Aspergillus flavus Isolates Originating from Serbian Wheat Grains. Acta Aliment. 2020, 49, 382–389. [Google Scholar] [CrossRef]
- Yu, J.J.; Whitelaw, C.A.; Nierman, W.C.; Bhatnagar, D.; Cleveland, T.E. Aspergillus flavus expressed sequence tags for identification of genes with putative roles in aflatoxin contamination of crops. FEMS Microbiol. Lett. 2004, 237, 333–340. [Google Scholar] [CrossRef] [Green Version]
- Sipos, P.; Peles, F.; Brassó, D.L.; Béri, B.; Pusztahelyi, T.; Pócsi, I.; Győri, Z. Physical and Chemical Methods for Reduction in Aflatoxin Content of Feed and Food. Toxins 2021, 13, 204. [Google Scholar] [CrossRef]
- Zeidan, R.; Ul-Hassan, Z.; Al-Thani, R.; Balmas, V.; Jaoua, S. Application of Low-Fermenting Yeast Lachancea thermotolerans for the Control of Toxigenic Fungi Aspergillus parasiticus, Penicillium verrucosum and Fusarium graminearum and Their Mycotoxins. Toxins 2018, 10, 242. [Google Scholar] [CrossRef] [Green Version]
- Ul Hassan, Z.; Al Thani, R.; Alnaimi, H.; Migheli, Q.; Jaoua, S. Investigation and Application of Bacillus licheniformis Volatile Compounds for the Biological Control of Toxigenic Aspergillus and Penicillium spp. ACS Omega 2019, 4, 17186–17193. [Google Scholar] [CrossRef]
- Alasmar, R.; Ul-Hassan, Z.; Zeidan, R.; Al-Thani, R.; Al-Shamary, N.; Alnaimi, H.; Migheli, Q.; Jaoua, S. Isolation of a Novel Kluyveromyces Marxianus Strain QKM-4 and Evidence of Its Volatilome Production and Binding Potentialities in the Biocontrol of Toxigenic Fungi and Their Mycotoxins. ACS Omega 2020, 5, 17637–17645. [Google Scholar] [CrossRef] [PubMed]
- Wilson, J.P.; Jurjevic, Z.; Hannah, W.; Wilson, D.M.; Potter, T.L.; Coy, A.E. Host-specific variation in infection by toxigenic fungi and contamination by mycotoxins in pearl millet and corn. Mycopathologia 2006, 161, 101–107. [Google Scholar] [CrossRef] [PubMed]
- Ranjbar, R.; Roayaei Ardakani, M.; Mehrabi Kushki, M.; Kazeminezhad, I. Identification of Toxigenic Aspergillus Species from Rice of Khuzestan and Mycotoxins in Imported Cereals. Iran J. Med. Microbiol. 2019, 13, 355–373. [Google Scholar] [CrossRef]
- Tabuc, C.; Marin, D.; Guerre, P.; Sesan, T.; Bailly, J.D. Molds and Mycotoxin Content of Cereals in Southeastern Romania. J. Food Prot. 2009, 72, 662–665. [Google Scholar] [CrossRef]
- Jedidi, I.; Cruz, A.; Gonzalez-Jaen, M.T.; Said, S. Aflatoxins and ochratoxin a and their aspergillus causal species in Tunisian cereals. Food Addit. Contam. Part B 2017, 10, 51–58. [Google Scholar] [CrossRef]
- Pitt, J.I.; Hocking, A.D. Fungi and Food Spoilage, 2nd ed.; Blackie Academic and Professional: London, UK, 1997. [Google Scholar]
- Thathana, M.; Murage, H.; Abia, A.; Pillay, M. Morphological Characterization and Determination of Aflatoxin-Production Potentials of Aspergillus Flavus Isolated from Maize and Soil in Kenya. Agriculture 2017, 7, 80. [Google Scholar] [CrossRef] [Green Version]
- Iheanacho, H.E.; Njobeh, P.B.; Dutton, F.M.; Steenkamp, P.A.; Steenkamp, L.; Mthombeni, J.Q.; Daru, B.H.; Makun, A.H. Morphological and Molecular Identification of Filamentous Aspergillus flavus and Aspergillus parasiticus Isolated from Compound Feeds in South Africa. Food Microbiol. 2014, 44, 180–184. [Google Scholar] [CrossRef]
- White, T.J.; Bruns, T.; Lee, S.; Taylor, J.W. Amplification and direct sequencing of fungal ribosomal RNA genes for phylogenetics. In PCR Protocols: A Guide to Methods and Applications; Innis, M.A., Gelfand, D.H., Sninsky, J.J., White, T.J., Eds.; Academic Press Inc.: New York, NY, USA, 1990; pp. 315–322. [Google Scholar]
- González-Salgado, A.; Patiño, B.; Vázquez, C.; González-Jaén, M.T. Discrimination of Aspergillus niger and other Aspergillus species belonging to section Nigri by PCR assays. FEMS Microbiol. Lett. 2005, 245, 353–361. [Google Scholar] [CrossRef]
- Oliveri, C.; Torta, L.; Catara, V. A polyphasic approach to the identification of ochratoxin A-producing black Aspergillus isolates from vineyards in Sicily. Int. J. Food Microbiol. 2008, 127, 147–154. [Google Scholar] [CrossRef]
- Makun, H.A.; Dutton, M.F.; Njobeh, P.B.; Mwanza, M.; Kabiru, A.Y. Natural multi-occurrence of mycotoxins in rice from Niger State, Nigeria. Mycotoxin Res. 2011, 27, 97–104. [Google Scholar] [CrossRef] [Green Version]
- European Commission. Commission Recommandation of 17 August 2006 on the Presence of Deoxynivalenol, Zearalenone, Ochratoxin A, T-2 and HT-2 and Fumonisins in Products Intended for Animal Feeding. 2006. Available online: http://eur-lex.europa.eu/legal-content/EN/TXT/PDF/?uri1⁄4CELEX:32006H0576&from1⁄4EN (accessed on 18 May 2022).
- European Union. Commission Regulation (EU) No 1058/2012 of 12 November 2012. Amending Regulation (EC) No 1881/2006 as regards maximum levels for aflatoxins in dried figs. Off. J. Eur. Union 2010, L313, 14–15. [Google Scholar]
- Giorni, P.; Magan, N.; Pietri, A.; Bertuzzi, T.; Battilani, P. Studies on Aspergillus section Flavi isolated from maize in northern Italy. Int. J. Food Microbiol. 2007, 113, 330–338. [Google Scholar] [CrossRef] [PubMed]
- Fiori, S.; Urgeghe, P.P.; Hammami, W.; Razzu, S.; Jaoua, S.; Migheli, Q. Biocontrol Activity of Four Non- and Low-Fermenting Yeast Strains against Aspergillus Carbonarius and Their Ability to Remove Ochratoxin A from Grape Juice. Int. J. Food Microbiol. 2014, 189, 45–50. [Google Scholar] [CrossRef] [PubMed] [Green Version]
- Farbo, M.G.; Urgeghe, P.P.; Fiori, S.; Marcello, A.; Oggiano, S.; Balmas, V.; Hassan, Z.U.; Jaoua, S.; Migheli, Q. Effect of Yeast Volatile Organic Compounds on Ochratoxin A-Producing Aspergillus carbonarius and A. Ochraceus. Int. J. Food Microbiol. 2018, 284, 1–10. [Google Scholar] [CrossRef]
- Hua, S.S.T.; Beck, J.J.; Sarreal, S.B.L.; Gee, W. The major volatile compound 2-phenylethanol from the biocontrol yeast, Pichia anomala, inhibits growth and expression of aflatoxin biosynthetic genes of Aspergillus flavus. Mycotoxin Res. 2014, 30, 71–78. [Google Scholar] [CrossRef]
- Al Attiya, W.; Hassan, Z.U.; Al-Thani, R.; Jaoua, S. Prevalence of Toxigenic Fungi and Mycotoxins in Arabic Coffee (Coffea Arabica): Protective Role of Traditional Coffee Roasting, Brewing and Bacterial Volatiles. PLoS ONE 2021, 16, e0259302. [Google Scholar] [CrossRef]
- Tilocca, B.; Balmas, V.; Hassan, Z.U.; Jaoua, S.; Migheli, Q. A Proteomic Investigation of Aspergillus carbonarius Exposed to Yeast Volatilome or to Its Major Component 2-Phenylethanol Reveals Major Shifts in Fungal Metabolism. Int. J. Food Microbiol. 2019, 306, 108265. [Google Scholar] [CrossRef]
- Balmas, V.; Migheli, Q.; Scherm, B.; Garau, P.; O’Donnell, K.; Ceccherelli, G.; Kang, S.; Geiser, D.M. Multilocus phylogenetics show high levels of endemic fusaria inhibiting Sardinian soils (Tyrrhenian island). Mycologia 2010, 4, 803–812. [Google Scholar] [CrossRef] [Green Version]
- Steel, R.G.D.; Torrie, J.H.; Dicky, D.A. Principles and Procedures of Statistics, A Biometrical Approach, 3rd ed.; McGraw Hill, Inc.: New York, NY, USA; Book Co.: New York, NY, USA, 1997; pp. 352–358. [Google Scholar]

| Item | Fungi Isolated | No. of Isolates | Isolation Frequency (%) | Relative Density (%) |
|---|---|---|---|---|
| Wheat (n = 17) | Aspergillus | 25 | 88.23 ± 13.33 a | 67.56 ± 11.73 |
| Penicillium | 3 | 11.76 ± 5.21 | 8.57 ± 2.27 b | |
| Rice (n = 14) | Aspergillus | 17 | 78.57 ± 14.81 a | 73.91 ± 16.20 |
| Penicillium | 2 | 14.28 ± 6.67 | 8.69 ± 0.94 b | |
| Maize (n = 13) | Aspergillus | 31 | 100 ± 0.00 a | 65.95 ± 8.59 |
| Penicillium | 7 | 30.76 ± 6.53 | 14.89 ± 3.36 a | |
| Oats (n = 14) | Aspergillus | 5 | 14.28 ± 3.25 b | 55.56 ± 7.31 |
| Penicillium | 0 | 0 | 0 | |
| Breakfast Cereals (n = 17) | Aspergillus | 0 | 0 | 0 |
| Penicillium | 0 | 0 | 0 |
| Item | Mycotoxin Concentration (μg/kg) | |||
|---|---|---|---|---|
| Aflatoxins (AFs) | Ochratoxin A (OTA) | |||
| Range (Min–Max) | Mean ± SD | Range (Min–Max) | Mean ± SD | |
| Wheat (n = 17) | ND *–3.14 | 2.81 ± 1.21 b | 1.91–2.79 | 2.31 ± 0.43 |
| Rice (n = 14) | ND–3.50 | 2.23 ± 1.07 b | 1.84–2.91 | 2.41 ± 1.43 |
| Maize (n = 13) | 1.93–6.7 | 3.89 ± 1.32 a | 1.57–2.58 | 2.05 ± 0.89 |
| Oats (n = 14) | 1.8–2.58 | 1.87 ± 0.86 b | 0 | 0 |
| Breakfast Cereals (n = 17) | 2.23–3.62 | 2.59 ± 1.60 b | 0 | 0 |
Publisher’s Note: MDPI stays neutral with regard to jurisdictional claims in published maps and institutional affiliations. |
© 2022 by the authors. Licensee MDPI, Basel, Switzerland. This article is an open access article distributed under the terms and conditions of the Creative Commons Attribution (CC BY) license (https://creativecommons.org/licenses/by/4.0/).
Share and Cite
Alkuwari, A.; Hassan, Z.U.; Zeidan, R.; Al-Thani, R.; Jaoua, S. Occurrence of Mycotoxins and Toxigenic Fungi in Cereals and Application of Yeast Volatiles for Their Biological Control. Toxins 2022, 14, 404. https://doi.org/10.3390/toxins14060404
Alkuwari A, Hassan ZU, Zeidan R, Al-Thani R, Jaoua S. Occurrence of Mycotoxins and Toxigenic Fungi in Cereals and Application of Yeast Volatiles for Their Biological Control. Toxins. 2022; 14(6):404. https://doi.org/10.3390/toxins14060404
Chicago/Turabian StyleAlkuwari, Asma, Zahoor Ul Hassan, Randa Zeidan, Roda Al-Thani, and Samir Jaoua. 2022. "Occurrence of Mycotoxins and Toxigenic Fungi in Cereals and Application of Yeast Volatiles for Their Biological Control" Toxins 14, no. 6: 404. https://doi.org/10.3390/toxins14060404
APA StyleAlkuwari, A., Hassan, Z. U., Zeidan, R., Al-Thani, R., & Jaoua, S. (2022). Occurrence of Mycotoxins and Toxigenic Fungi in Cereals and Application of Yeast Volatiles for Their Biological Control. Toxins, 14(6), 404. https://doi.org/10.3390/toxins14060404

